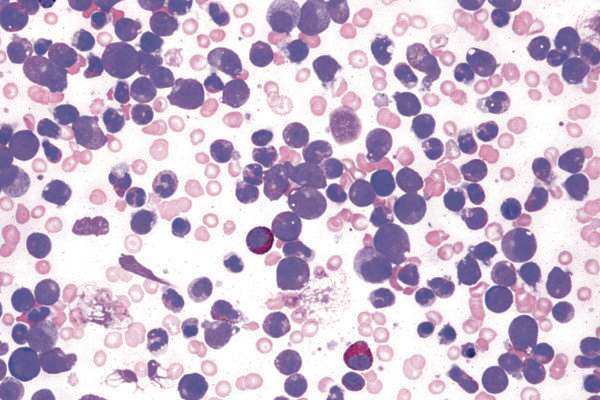

במחקר פורץ דרך הצליחה לאחרונה קבוצת חוקרים מהפקולטה לרפואה של האוניברסיטה העברית בירושלים לפתח תרופה ביולוגית יעילה נגד מחלת סרטן הדם הקשה, לוקמיה מיאלואידית חריפה.
קבוצת החוקרים, בהובלת פרופ' ינון בן־נריה, מצאה כי לתרופה הניסיונית היתה יכולת ריפוי של כ־50 אחוזים בחיות מעבדה שנושאות את הלוקמיה. פריצת הדרך התאפשרה בעקבות שיתוף פעולה יוצא דופן עם הקרן למחקר רפואי של ד"ר מרים ושלדון אדלסון (AMRF).
לוקמיה מיאלואידית חריפה (AML) היא מחלה שפוגעת בתאי מח העצם ובייצור תאי דם לבנים. פגיעה זו גורמת לכך שתאי דם לבנים מתרבים בלי בקרה ומצטברים במח העצם, מבלי שהבשילו. במצב כזה מח העצם אינו יכול לייצר תאי דם. כתוצאה מכך סובלים החולים מאנמיה וממחסור בתאי דם אדומים, וכן ממחסור בטסיות דם ומדימומים. בשל מחסור בתאי דם לבנים נפגעת יכולתו של הגוף להתמודד עם זיהומים. מדובר במחלה נדירה יחסית: מדי שנה מאובחנים בישראל כ־300 חולים (0.8 אחוזים מכלל אבחנות הסרטן), כמחציתם ילדים.
הטיפול העיקרי ולמעשה הכמעט יחיד בלוקמיה מסוג זה, הוא כימותרפיה. חלק מהחולים מצליחים להשיג הפוגה במחלה ואף להגיע להחלמה לאחר טיפול כימותרפיה. טיפולים נוספים כוללים השתלת תאי גזע או השתלת מח עצם.
זוכה להדים בעולם
התרופה הניסיונית החדשה שפותחה על ידי פרופ' בן־נריה ועמיתיו מכילה מולקולה קטנה שעובדת כטיפול מכוון ורב־זרועי. מולקולה זו תוקפת כמה חלבוני מפתח לוקמיים בצמתים שונים, ומקשה מאוד על התא הממאיר להתחמק מטיפול. מתקפה רב־חזיתית זו כנגד התא הלוקמי הופכת את התרופה הניסיונית ליעילה אף יותר מטיפול משולב של כמה תרופות. ידוע גם שאחת הסיבות לקושי לרפא לוקמיה היא עמידות תאי הגזע הממאירים לכימותרפיה, ובמחקר החדשני התגלה שהתרופה החדשה מסוגלת להכחיד תאי גזע לוקמיים עמידים לכימותרפיה ולמנוע התפרצות מחודשת של המחלה.
לאור הצלחה זו, רכשה חברת "ביותריקס" מארה"ב את זכויות הפיתוח של התרופה מחברת "יישום", חברת הפיתוח והמחקר של האוניברסיטה העברית. בימים אלו מקדמת החברה, בשיתוף קבוצת החוקרים, צעדים לקראת אישור של ניסוי קליני - בפאזה הראשונה בחולי לוקמיה במרכזים רפואיים מובילים בארה״ב. הניסוי הקליני הוא צעד הכרחי וחשוב לבחינת יעילות התרופה בבני אדם, ורק לאחר שיאושרו ויבוצעו הניסויים בבני אדם ותוכח אצלם יעילות התרופה, היא תוכל להיות זמינה לטיפול בחולים כתרופה פורצת דרך.
פרופ' בן־נריה מבית הספר לרפואה באוניברסיטה העברית הוא רופא בהכשרתו ועוסק בעיקר במחקר רפואה, והמומחיות שלו היא במודלים ביולוגיים של מחלות סרטן. בן־נריה אמר אתמול ל"ישראל היום" כי "אנחנו כבר מקבלים הרבה מאוד הדים בעולם המדע ברחבי העולם, וגם בכירי הרופאים ההמטולוגים בארץ ובעולם כבר מחכים להמשך הניסויים בתרופה".
על פי המחקר, המולקולה הניסיונית עובדת באופן ייחודי בכך שהיא מדמה שילוב של לפחות 3-4 תרופות קיימות, כאשר ביחד היא עובדת יותר טוב מאשר אם כל התרופות היו ניתנות כל אחת בנפרד באותו הזמן.
גילוי נאות: ד"ר מרים אדלסון היא מו"ל "ישראל היום". משפחת אדלסון היא הבעלים של החברה המחזיקה במניות "ישראל היום"
את הסטורי שלנו כבר בדקתם היום? הצטרפו כאן לאינסטגרם של ישראל היום